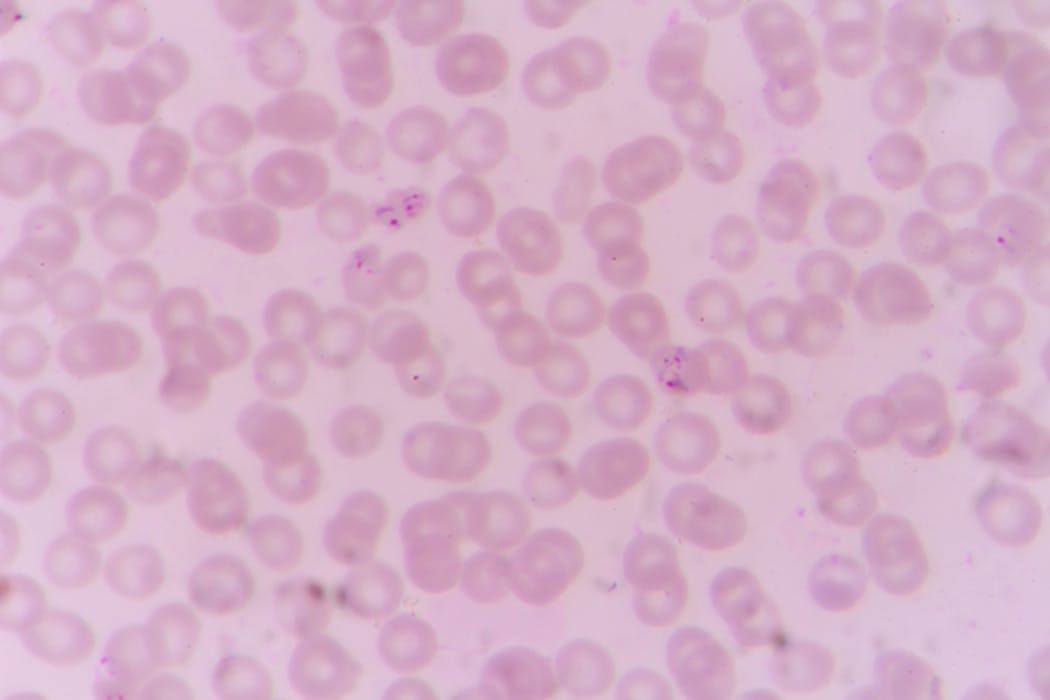

Chadsikan Tawanthaisong/Shutterstock
Musim hujan telah tiba dan banyak air tergenang di sekitar rumah. Lingkungan kotor seperti itu yang menjadi tempat favorit nyamuk untuk berkembangbiak. Nyamuk malaria menggigit tubuh manusia mulai magrib sampai pagi. Malaria merupakan penyakit yang menyebar melalui gigitan nyamuk yang terinfeksi parasit Plasmodium. Satu gigitan saja bisa menyebabkan parasit masuk ke aliran darah.
Dan kini malaria sudah muncul di lebih dari seratus negara. Separuh populasi manusia di seluruh dunia berada dalam risiko tertular penyakit malaria. Gejala umum terserang malaria: pusing, panas, mual, hilang kesadaran kalau yang sudah ekstrim. Jika sel darah merah dalam tubuh sangat berkurang bisa menyebabkan malaria otak.
Malaria merupakan musuh bebuyutan umat manusia. Perang panjang manusia versus penyakit malaria sudah berlangsung ratusan tahun. Tapi mengapa perang itu belum berakhir?
Malaria telah membunuh banyak manusia sejak 4000 tahun terakhir. Di Cina, para tabib sudah mencatat kasus gejala malaria malaria sejak 2700 tahun sebelum Masehi. Begitu pun catatan dari Yunani dan Romawi kuno.
Hingga pada akhir abad ke-19, Charles Laveran, dokter dari Prancis, menemukan biang keladi malaria yaitu Parasit Plasmodium. Temuan ini membuat Laveran menerima Hadiah Nobel Kedokteran pada 1907 dan membawa perang malaria ke babak baru.
Tidak mudah mengontrol malaria, karena penyakit ini punya sifat biologi yang unik. Gen parasit dari satu spesies banyak sekali dan masing-masing gen mempunyai fungsi masing-masing. Ada gen yang bisa berubah, misalnya, saat kena obat atau sistem imunnya manusia bagus. Gen berubah sehingga parasit juga berubah.
Rintis Noviyanti, peneliti malaria dari Lembaga Eijkman di Jakarta ikut berperang melawan malaria di tanah air. Para ilmuwan telah menemukan lima jenis parasit penyebab penyakit malaria pada manusia. Deteksi dini yang cepat dan akurat mampu mengurangi tingkat kematian akibat malaria.
Edisi ke-40 Sains Sekitar Kita ini disiapkan oleh Ikhsan Raharjo dan narator Malika. Selamat mendengarkan!